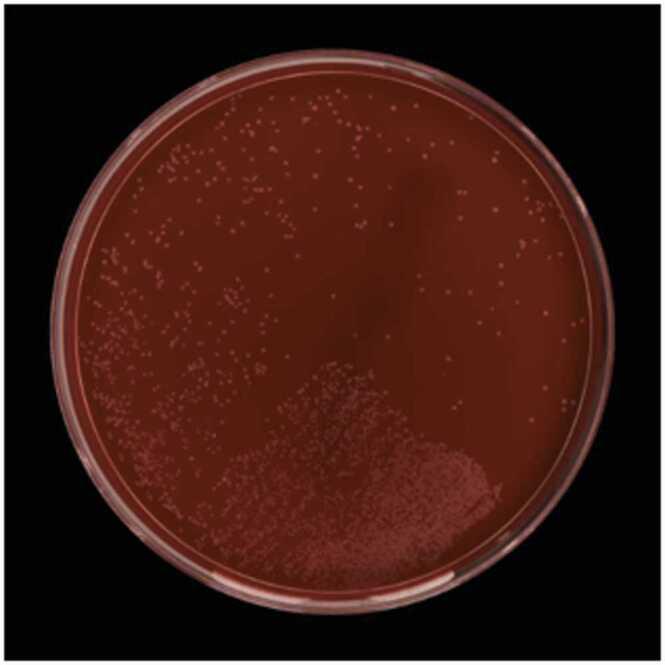
https://cdn.ncbi.nlm.nih.gov/pmc/blobs/3667/10461115/29a6379fec05/gr1.jpg

一名急性髓系白血病合并口腔炎患者的菌血症:一种新出现的病原体。
bacteremia in a patient with acute myeloid leukemia and stomatitis: An emerging pathogen.
作者信息
Sabrie Nasruddin Ali Salad, Halani Sheliza, Maguire Finlay, Aftanas Patryk, Kozak Robert, Andany Nisha
机构信息
Department of Medicine, University of Toronto, Canada.
Shared Hospital Laboratory, Canada.
出版信息
IDCases. 2023 Jul 3;33:e01837. doi: 10.1016/j.idcr.2023.e01837. eCollection 2023.
BACKGROUND
is a newly described, obligately anaerobic gram-positive bacillus. The first report of invasive disease caused by was described in a patient with acute lymphocytic leukemia following systematic chemotherapy. Here we describe another case of bacteremia in a patient with a hematologic malignancy following chemotherapy-induced neutropenia.
METHODS
We present a case of a 46-year-old woman with a recent diagnosis of AML who presented to Sunnybrook Health Sciences Center with febrile neutropenia following induction chemotherapy with daunorubicin-cytarabine (3 +7 regimen) with Gemtuzumab and Ozogamycin. Despite being on intravenous pipercillin-tazobactam she remained febrile. Following our clinical assessment and investigations, potential sources of infection included a swollen digit and severe mucositis.
RESULTS
One blood culture from admission grew in the anaerobic bottle, identified by Matrix-Assisted Laser Desorption Ionization-Time of Flight (MALDI-TOF). The isolate also underwent whole-genome sequencing using methods that have been described previously. Results demonstrated the organism was susceptible to cefoxitin, clindamycin, meropenem, metronidazole, penicillin, and piperacillin-tazobactam. We concluded that the source of this patient's bloodstream infection to be chemotherapy-induced stomatitis.
CONCLUSION
With the increasing use of intensive immunosuppressive regimens and hematopoietic stem cell transplantation for patients with hematologic malignancies, there has been an increase in the incidence and detection of bloodstream infections due to anaerobic organisms. This is only the second case report of bacteremia, highlighting its emerging role as an opportunistic pathogen in immunocompromised patients.
背景
[细菌名称]是一种新描述的专性厌氧革兰氏阳性杆菌。首例由[细菌名称]引起的侵袭性疾病报告见于一名接受系统化疗后的急性淋巴细胞白血病患者。在此,我们描述另一例化疗引起中性粒细胞减少的血液系统恶性肿瘤患者发生[细菌名称]菌血症的病例。
方法
我们报告一例46岁女性,近期诊断为急性髓系白血病(AML),在接受柔红霉素-阿糖胞苷(3 +7方案)联合吉妥单抗和奥佐米星诱导化疗后,因发热性中性粒细胞减少症就诊于桑尼布鲁克健康科学中心。尽管静脉使用哌拉西林-他唑巴坦,她仍持续发热。经过临床评估和检查,潜在感染源包括手指肿胀和严重的粘膜炎。
结果
入院时采集的一份血培养在厌氧瓶中培养出[细菌名称],通过基质辅助激光解吸电离飞行时间质谱(MALDI-TOF)鉴定。该分离株还采用先前描述的方法进行了全基因组测序。结果表明该菌株对头孢西丁、克林霉素、美罗培南、甲硝唑、青霉素和哌拉西林-他唑巴坦敏感。我们得出结论,该患者血流感染的来源是化疗引起的口腔炎。
结论
随着血液系统恶性肿瘤患者强化免疫抑制方案和造血干细胞移植的使用增加,厌氧生物引起的血流感染的发生率和检出率有所上升。这仅是第二例[细菌名称]菌血症病例报告,凸显了其作为免疫受损患者机会性病原体的新出现作用。